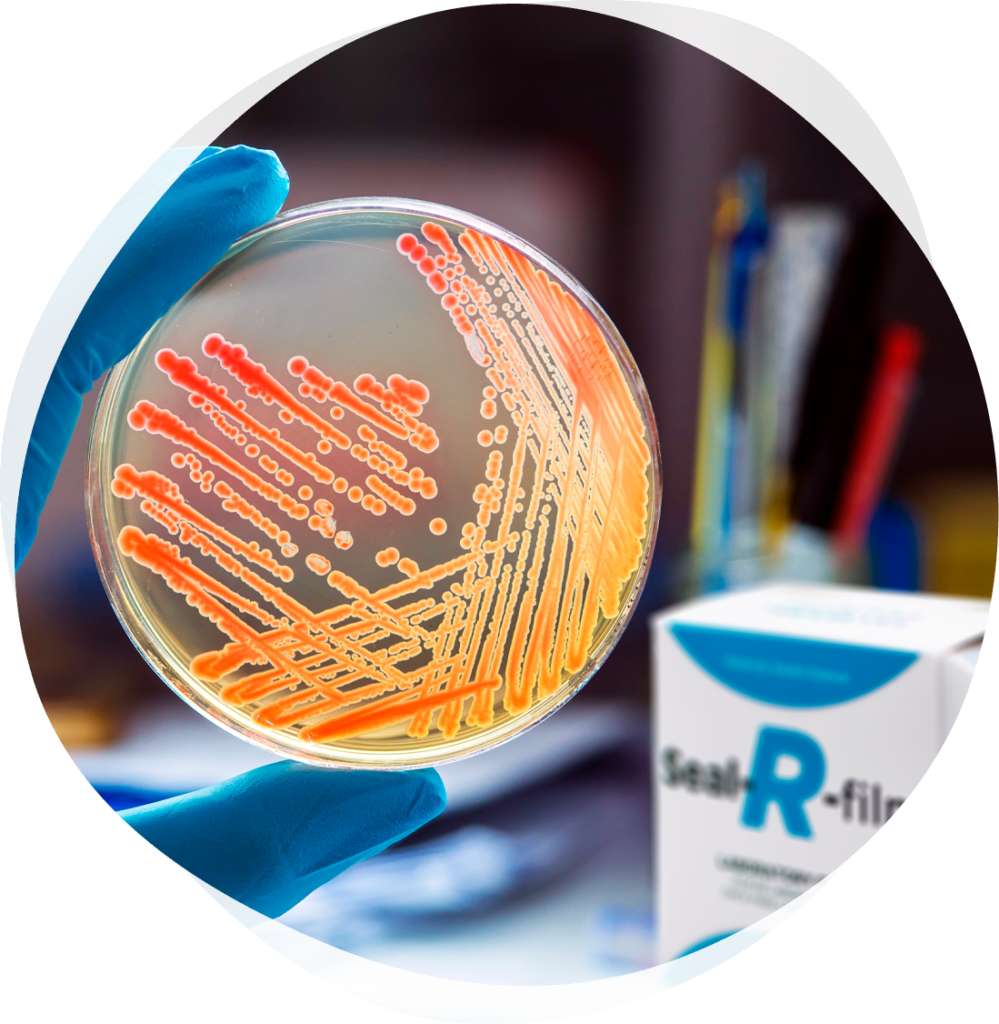

- Panama
- sales@sealrfilm.com
- Horario de Oficina: 8 – 5 PM
- English
Especialistas en cinta de laboratorio #PerfeclySealedScience
Seal-R-Film®
Descripción de producto


Perfectly Sealed Science
Somos una cinta de laboratorio de alta calidad, semi-translúcida, flexible, auto-sellante y resistente a la humedad. ¡Siempre en stock! ¡No más pedidos pendientes ni tiempos de espera para obtener la cinta de laboratorio! Disponible en 4 tamaños diferentes.

Características Diferenciadoras

Se expande hasta un 500%
Nuestra cinta se expande realmente 5 veces en ancho y 4 veces en alto, proporcionando un uso más cómodo para un sellado perfecto.


Ajuste perfecto
No más derrames, evaporación ni contaminación, sella perfectamente vasos, matraces, cajas petri y otros recipientes, siempre se ajusta, aún en superficies irregulares.


Mayor claridad
Hasta un 95% de claridad una vez aplicado en cualquier recipiente, perfecto para conteos y visiblidad.

Sin derrames
La cinta es semi transparente, con claridad al expandir, sella perfecto cubriendo todos los recipientes lo que evita derrames y contaminaciones.

Medidas Disponibles

PRC 2250 ROLL
2in x 250 ft
5.08 cm x 76.2 m

PRC 4125 ROLL
4in x 250 ft
10.16 cm x 38.1 m

PRC 4250 ROLL
4in x 250 ft
10.16 cm x 76.2 m

PRC 2050 ROLL
20in x 50 ft
50.8 cm x 15.24 m


